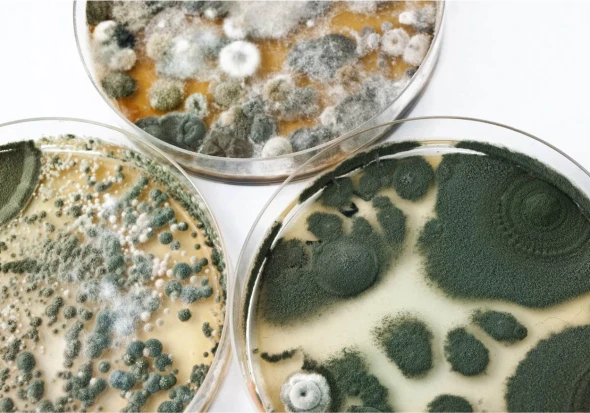

Seit 2003 ein Begriff für: Leistungsstärke, Termintreue, gute Qualität und preisWERTe Ausführung
Herzlich willkommen, allen neuen und alten Kunden, sowie allen Interessierten auf unserer Internetplattform. Wir sind ein seit 2003 bestehender Malerfachbetrieb mit Sitz in Duisburg und seit 2011 mit einem Zweitsitz in Empfingen. Unser Malerbetrieb führt für Sie aus: Wärmedämmung WDVS, Fassadenbeschichtungen, Betoninstandsetzung, Umbau, Ausbau, Sanierung, Graffitientfernung, Graffitischutzsysteme, Gebäudereinigung, Gebäudeabdichtungen, Parkplatz- und Fahrbahnmarkierungen, Bodenbeläge aller Art, Schimmelbeseitigung und Schimmelschutz, Sanierung, Wasserschadenregulierung direkt mit Ihrer Versicherung, Urlaubsservice, Malertechnik, Beschriftung, Bautrocknung und Malerarbeiten aller Art. Ob Ausbau, Umbau, Neubau und / oder Sanierung, bei uns bekommen Sie alle Leistungen aus einer Hand! Sprechen Sie uns an.
Unsere Leistungen im Überblick!
Flyer Downloads

Unsere Preise: Malerarbeiten in Ihrer Stadt unschlagbar günstig!
Mit unserer Preiskalkulationssoftware erstellen wir Ihnen innerhalb von wenigen Minuten den besten Preis für Ihre Anfrage. Automatisch werden alle notwendigen Arbeitszeiten und Materialien kalkuliert und detailliert aufgeführt. Beispielsweise können wir preiswert und günstig die komplette Schimmelbeseitigung ab 159 Euro und das weiße Streichen einer 100-Quadratmeter-Fassade ab 1.499 Euro anbieten.

Wir möchten, dass Sie zufrieden sind und sich Ihr Wunschprojekt so entwickelt, wie Sie es sich vorstellen. Deshalb arbeiten wir nicht nur zuverlässig, sauber und qualitativ, sondern vor allem legen wir viel Wert auf eine kompetente Beratung und Umsetzung.
Dazu gehören auch aktuelle Trends, angesagte Stile und Nachhaltigkeit. Wir beraten Sie gern und sind dabei immer ehrlich und fachlich versiert. Zudem legen wir Wert auf Transparenz in der Angebotserstellung. Wir möchten für Sie moderne Wohnkonzepte entwickeln und mit viel Liebe zum Detail für Sie und mit Ihnen Farben, Tapeten, Muster und Materialien aussuchen.
Zögern Sie nicht und fordern Sie Ihr individuelles Angebot an. Wir helfen auch gerne bei der Umsetzung eines gewünschten Tapetenwechsels, kommen unverbindlich vorbei und geben Ihnen vor Ort ein freies Angebot ab.

Sie wünschen sich einen Tapetenwechsel? Auch dabei helfen wir Ihnen gern. Wir tapezieren mit Raufaser-, Vinyl-, Struktur-, Seiden-, Glasfaser- und Mustertapete und verhelfen Ihnen zu stimmungsvollen, hochwertigen Wohnraumkonzepten. Dazu gehört natürlich auch die dekorative Gestaltung rund um Marmorieren, Spachteltechniken, Lasuren, Steinimitaten und Sprenkeltechniken.
Für etwas mehr Glanz sorgen unsere Lackierarbeiten rund um Lackeffekte, Spritzlackierungen, Brandschutzlackierungen sowie Hoch- und Niederdrucklackierungen.